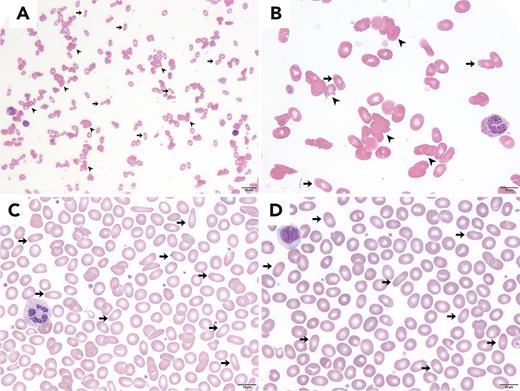
graphic

A previously healthy 5-month-old female infant presented with a 3-day history of pallor. Her medical history included neonatal hyperbilirubinemia requiring phototherapy. Both parents were healthy. Physical examination revealed tachycardia and marked pallor without jaundice or hepatosplenomegaly. A complete blood count showed hemoglobin level 3.5 g/dL, white blood cell count 11.4 × 109/L, platelet count 170 × 109/L, and reticulocyte count 0.3%. Peripheral blood smear (PBS) images (panels A, B: Wright-Giemsa stain, 40× and 100× objective, respectively) demonstrated red cell agglutination (arrowheads) with numerous elliptocytes (arrows) but no polychromasia. Direct antiglobulin test was 3+ for both immunoglobulin G (IgG) and C3d. Parvovirus B19 IgM and IgG were positive. Elliptocytes (arrows) were also observed in her father’s PBS (panel C: Wright-Giemsa stain, 100× objective). The heterozygous spectrin Chiang Mai mutation (SPTB c.6224A>G, p.E2075G) was confirmed in both the patient and father. The definitive diagnosis was parvovirus B19-induced autoimmune hemolytic anemia (AIHA) and hereditary elliptocytosis. The patient was treated with methylprednisolone and received 4 red cell transfusions. She achieved complete remission of AIHA 2 months after diagnosis, with only elliptocytes (arrows) remaining on PBS (panel D: Wright-Giemsa stain, 100× objective).
This case highlights the importance of PBS in differentiating AIHA from pure red cell aplasia in patients with parvovirus B19 infection. Additionally, PBS can help reveal underlying red cell membrane disorders in patients with AIHA.
For additional images, visit the ASH Image Bank, a reference and teaching tool that is continually updated with new atlas and case study images. For more information, visit https://imagebank.hematology.org.